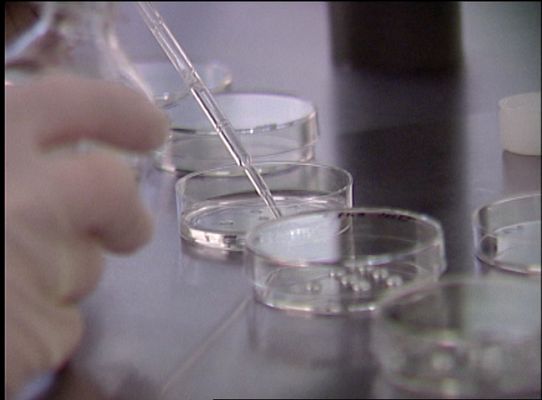
Telediario 1 - Bebé libre de un gen del cáncer

Telediario 1
Bebé libre de un gen del cáncer
El niño tenía un 60% de posibilidades de desarrollar la enfermedad. Ha sido posible gracias a la selección de embriones sin mutaciones genéticas,...
17/03/2011 00:01:21